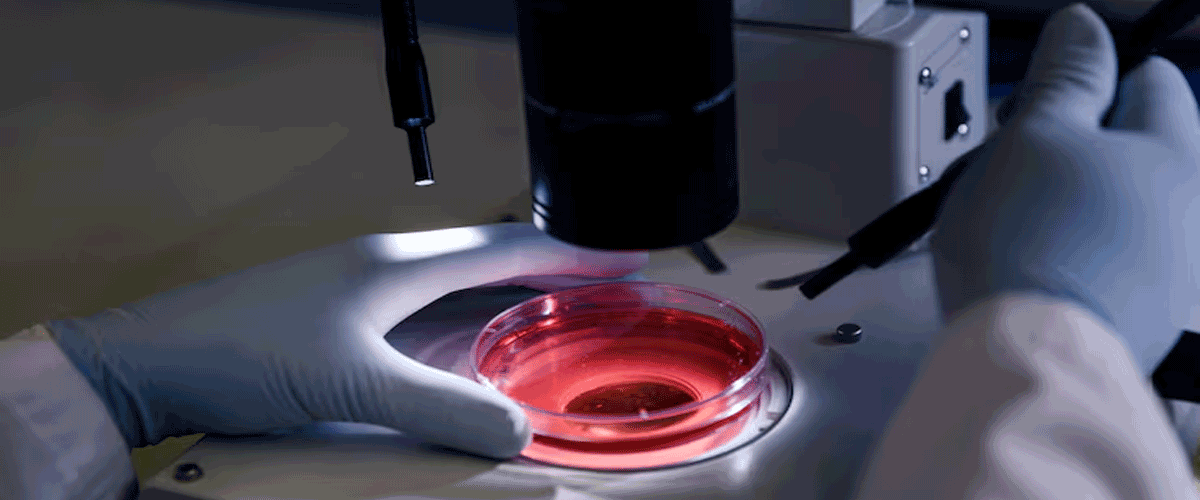
Overture’s DaVitri Gains CE Mark to Automate IVF Embryo Vitrification

(An Autonomous Body Recognized by Ministry of Commerce & Industry, Government of India)
Competency based placement focussed Education | Training | Research | Consultancy
Overture’s DaVitri Gains CE Mark to Automate IVF Embryo Vitrification
Overture Life’s DaVitri system, an automated in vitro fertilisation (IVF) platform, has received a CE mark in Europe, positioning the Spain-headquartered company to expand commercialisation across Europe and the UK. The benchtop system automates the vitrification of mature oocytes, a technically demanding step in IVF that involves fast-freezing embryos in a glasslike state. By using microfluidics, robotics, and cloud connectivity, DaVitri reduces operator variability and standardises egg thawing and freezing, aiming to improve embryo formation outcomes.
Overture is also conducting a US non-inferiority study comparing DaVitri with manual vitrification, with blastocyst development as the primary endpoint. Rising infertility rates, delayed parenthood, and growing adoption of assisted reproductive technologies (ART) are driving IVF uptake in Europe, with over 1.1 million cycles reported in 2021. Overture plans to integrate artificial intelligence to further enhance embryo selection and optimise IVF success, supported by a €20 million European Investment Bank loan for AI development.
25-11-2025
📰 Recent News
- Medtronic Expands Stealth AXiS System with FDA Clearance for Cranial and ENT Use
- Watchman Device Matches Blood Thinners in Stroke Prevention Trial
- Medtronic Secures CE Mark for Next-Generation Defibrillation Lead
- Philips Gains FDA Clearance for AI-Driven Cardiac Imaging Tool
- Medtronic Secures FDA Approval for Advanced Defibrillation Lead
- GE HealthCare Enters Photon-Counting CT Market with FDA Clearance
- Telesurgery Gains Momentum as SS Innovations and XCath Advance Robotic Care
- Medtronic Expands Pain Portfolio with ViaVerte Distribution Deal
- Samsung Medison Unifies US Imaging Units Under New Brand Identity
- Cerebral Expands ADHD Care with Inflow Acquisition Amid Rising Cases
